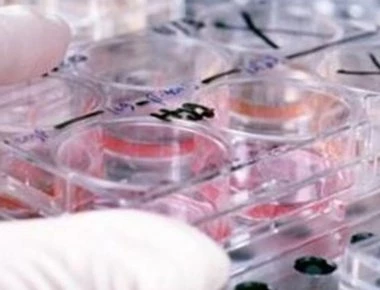
Η ασθένεια «μάστιγα» στις ανεπτυγμένες χώρες- Σκοτώνει περισσότερους και από το AIDS

ΥΓΕΙΑ
-

Αν πίνετε για να ξεχάσετε τότε κάνετε λάθος, αφού το αλκοόλ βελτιώνει τη μνήμη
Την άποψη ότι «πίνω για να ξεχάσω» αντικρούει κατέδειξε ότι ενδέχεται να βελτιώνει (και όχι να πλήττει) τη μνήμη, τουλάχιστον παροδικά. Ωστόσο η βελτίωση αφορά αναμνήσεις που δημιουργούνται πριν από τ...
Read More » -

Οι εγκέφαλοι των έξυπνων ατόμων διαφέρουν από τους αυτούς των κοινών θνητών
Οι άνθρωποι με "έξυπνο" εγκέφαλο έχουν πιο πολλές πιθανότητες να είναι ευτυχισμένοι, μορφωμένοι και πιο καλοπληρωμένοι.Όσοι τα καταφέρνουν καλύτερα έχουν εγκεφάλους που είναι διαφορετικά «δικτυωμένοι»...
Read More » -

Τι θα συμβεί αν βάλουμε λεμόνια δίπλα στο κρεβάτι
Δοκιμάστε το απόψε το βράδυ. Κόψτε ένα λεμόνι και βάλτε το δίπλα στο κρεβάτι σας. Το πρωί… Θα χαλαρώσετε Το άρωμα των εσπεριδοειδών ηρεμεί το νευρικό σύστημα, μειώνει το άγχος και βοη...
Read More » -
Η ασθένεια «μάστιγα» στις ανεπτυγμένες χώρες- Σκοτώνει περισσότερους και από το AIDS
Η ιογενής ηπατίτιδα έχει πλέον εξελιχθεί σε μία από τις κυριότερες αιτίες θανάτου στη Γη, σκοτώνοντας κάθε χρόνο τουλάχιστον τόσους ανθρώπους όσους η φυματίωση, η ελονοσία ή το AIDS, σύμφωνα με μια νέ...
Read More » -

Καρδιακές νόσοι και ψυχιατρικές παθήσεις πλήττουν τους οικονομικά αδύναμους
Yψηλά ποσοστά καρδιακής νόσου και υπέρτασης καθώς και ιδιαίτερα αυξημένα ποσοστά ψυχιατρικών παθήσεων, παρατηρήθηκαν σε οικονομικά αδύναμους και ανασφάλιστους ασθενείς που εξετάστηκαν στο Κέντρο Υποδο...
Read More » -

Προσευχή για απαλλαγή από την κατάθλιψη
Η εποχή μας χαρακτηρίζεται εποχή της παράκρουσης και τα προβλήματα και οι ατυχίες είναι ένα κομμάτι της ζωής. Ο καθένας, ιδίως στις μέρες μας, βιώνει τη δυστυχία και πολλοί άνθρωποι μπορεί να βιώσουν ...
Read More » -

Νέα έρευνα: Η ασπιρίνη μετά από «μίνι» εγκεφαλικό μπορεί να σας σώσει
Η επείγουσα χορήγηση ασπιρίνης αμέσως μετά από μικρά εγκεφαλικά μπορεί να προλάβει τα σοβαρότερα αντίστοιχα επεισόδια, σύμφωνα με μια νέα ευρωπαϊκή επιστημονική έρευνα. Η μελέτη επισημαίνει ότι είχε υ...
Read More » -

«Μπαίνοντας» στο μυαλό των κατά συρροή δολοφόνων
Τα εγκλήματά τους είναι επαναλαμβανόμενα και συνήθως ειδεχθή, συγκλονίζοντας την κοινή γνώμη. Κατά συρροή δολοφόνοι (serial killers) ορίζονται, σύμφωνα με την αστυνομία, τα άτομα εκείνα που αφαιρούν τ...
Read More » -

Ήρθε και στην Ελλάδα νέα θεραπεία για την πολλαπλή σκλήρυνση
Η πεγκυλιωμένη ιντερφερόνη βήτα-1α εντάχθηκε πρόσφατα στη θετική λίστα συνταγογραφούμενων φαρμάκων, μετά την έγκρισή της για τη θεραπεία ενηλίκων ασθενών με υποτροπιάζουσα-διαλείπουσα πολλαπλή σκλήρυν...
Read More » -

Καρκίνος του πνεύμονα: Μπορούμε να μειώσουμε τις πιθανότητες εμφάνισης;
Οι πνεύμονες αποτελούν ένα από τα ζωτικά όργανα και το βασικότερο μέρος του αναπνευστικού συστήματος.Ο αέρας που εισέρχεται από το στόμα και τη μύτη προωθείται προς τον λάρυγγα και την τραχεία και από...
Read More »
